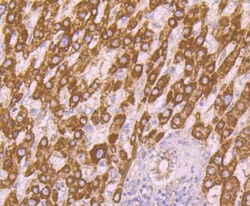

PA5-119665
antibody from Invitrogen Antibodies
Targeting: AMBP
EDC1, HCP, HI30, IATIL, ITI, ITIL, ITILC, UTI
Antibody data
- Antibody Data
- Antigen structure
- References [0]
- Comments [0]
- Validations
- Immunocytochemistry [6]
- Immunohistochemistry [3]
- Flow cytometry [2]
Submit
Validation data
Reference
Comment
Report error
- Product number
- PA5-119665 - Provider product page

- Provider
- Invitrogen Antibodies
- Product name
- alpha-1 Microglobulin Polyclonal Antibody
- Antibody type
- Polyclonal
- Antigen
- Recombinant full-length protein
- Description
- Positive Control: Human liver, Mouse liver, Mouse brain, Hela, HepG2, MCF-7, human liver tissue, human liver cancer tissue, human kidney tissue. Subcellular Location: Secreted.
- Reactivity
- Human, Mouse
- Host
- Rabbit
- Isotype
- IgG
- Vial size
- 100 μL
- Concentration
- 1 mg/mL
- Storage
- Store at 4°C short term. For long term storage, store at -20°C, avoiding freeze/thaw cycles.
No comments: Submit comment
Supportive validation
- Submitted by
- Invitrogen Antibodies (provider)
- Main image

- Experimental details
- Immunocytochemistry-Immunofluorescence analysis of AMBP in HepG2 cells (green) using alpha-1 Microglobulin Polyclonal Antibody (Product # PA5-119665). The nuclear counter stain is DAPI (blue). Cells were fixed in paraformaldehyde, permeabilised with 0.25% Triton X100/PBS.
- Submitted by
- Invitrogen Antibodies (provider)
- Main image

- Experimental details
- Immunocytochemistry-Immunofluorescence analysis of AMBP in MCF-7 cells (green) using alpha-1 Microglobulin Polyclonal Antibody (Product # PA5-119665). The nuclear counter stain is DAPI (blue). Cells were fixed in paraformaldehyde, permeabilised with 0.25% Triton X100/PBS.
- Submitted by
- Invitrogen Antibodies (provider)
- Main image

- Experimental details
- Immunocytochemistry-Immunofluorescence analysis of AMBP in Hela cells (green) using alpha-1 Microglobulin Polyclonal Antibody (Product # PA5-119665). The nuclear counter stain is DAPI (blue). Cells were fixed in paraformaldehyde, permeabilised with 0.25% Triton X100/PBS.
- Submitted by
- Invitrogen Antibodies (provider)
- Main image

- Experimental details
- Immunocytochemistry-Immunofluorescence analysis of AMBP in HepG2 cells (green) using alpha-1 Microglobulin Polyclonal Antibody (Product # PA5-119665). The nuclear counter stain is DAPI (blue). Cells were fixed in paraformaldehyde, permeabilised with 0.25% Triton X100/PBS.
- Submitted by
- Invitrogen Antibodies (provider)
- Main image

- Experimental details
- Immunocytochemistry-Immunofluorescence analysis of AMBP in MCF-7 cells (green) using alpha-1 Microglobulin Polyclonal Antibody (Product # PA5-119665). The nuclear counter stain is DAPI (blue). Cells were fixed in paraformaldehyde, permeabilised with 0.25% Triton X100/PBS.
- Submitted by
- Invitrogen Antibodies (provider)
- Main image

- Experimental details
- Immunocytochemistry-Immunofluorescence analysis of AMBP in Hela cells (green) using alpha-1 Microglobulin Polyclonal Antibody (Product # PA5-119665). The nuclear counter stain is DAPI (blue). Cells were fixed in paraformaldehyde, permeabilised with 0.25% Triton X100/PBS.
Supportive validation
- Submitted by
- Invitrogen Antibodies (provider)
- Main image
- Experimental details
- Immunohistochemistry (Paraffin) analysis of paraffin-embedded human liver cancer tissue using alpha-1 Microglobulin Polyclonal Antibody (Product # PA5-119665). Counter stained with hematoxylin.
- Submitted by
- Invitrogen Antibodies (provider)
- Main image

- Experimental details
- Immunohistochemistry (Paraffin) analysis of paraffin-embedded human liver tissue using alpha-1 Microglobulin Polyclonal Antibody (Product # PA5-119665). Counter stained with hematoxylin.
- Submitted by
- Invitrogen Antibodies (provider)
- Main image

- Experimental details
- Immunohistochemistry (Paraffin) analysis of paraffin-embedded human kidney tissue using alpha-1 Microglobulin Polyclonal Antibody (Product # PA5-119665). Counter stained with hematoxylin.
Supportive validation
- Submitted by
- Invitrogen Antibodies (provider)
- Main image

- Experimental details
- Flow Cytometry analysis of alpha-1 Microglobulin in HepG2 cells using alpha-1 Microglobulin Polyclonal Antibody (Product # PA5-119665) at 1:100 dilution (red) compared with an unlabelled control (cells without incubation with primary antibody; black). Alexa Fluor 488-conjugated goat anti-rabbit IgG was used as the secondary antibody.
- Submitted by
- Invitrogen Antibodies (provider)
- Main image

- Experimental details
- Flow Cytometry analysis of alpha-1 Microglobulin in HepG2 cells using alpha-1 Microglobulin Polyclonal Antibody (Product # PA5-119665) at 1:100 dilution (red) compared with an unlabelled control (cells without incubation with primary antibody; black). Alexa Fluor 488-conjugated goat anti-rabbit IgG was used as the secondary antibody.
 Explore
Explore Validate
Validate Learn
Learn Western blot
Western blot Immunocytochemistry
Immunocytochemistry